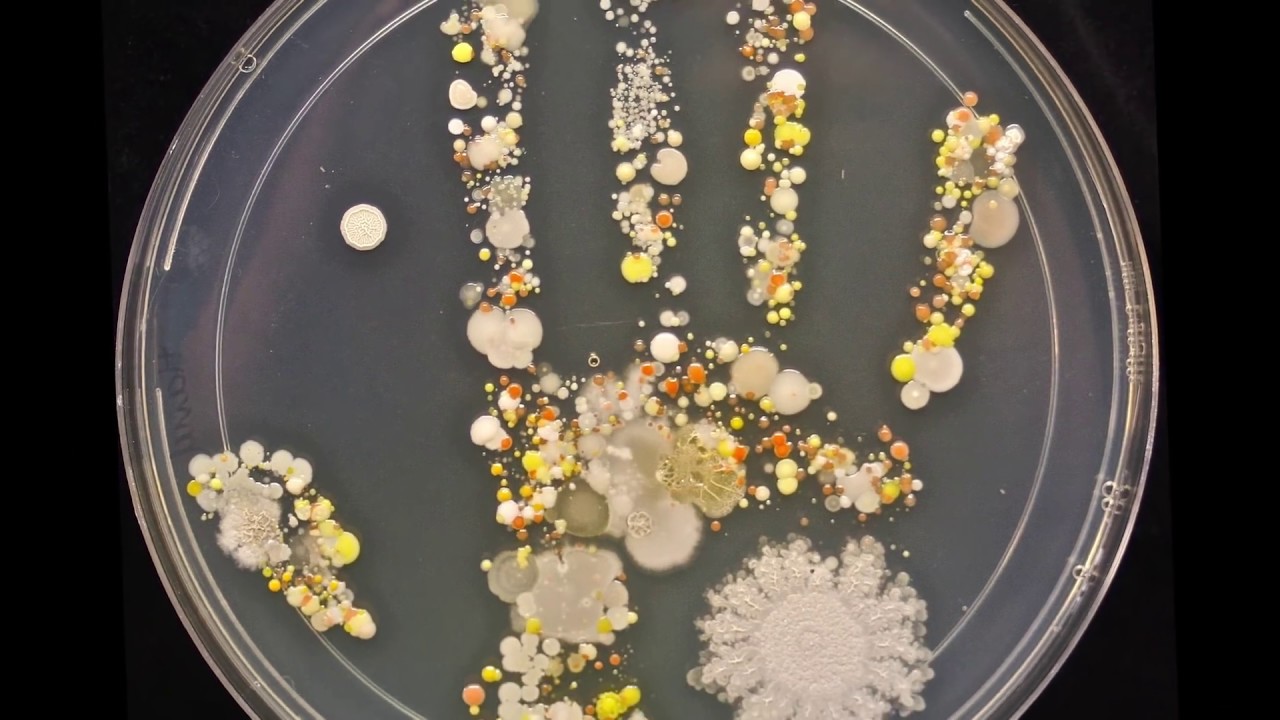
YouTube

Meet Your Microbes: Museum Exhibit Reveals a 'Secret World'

NEW YORK — Any time we look in the mirror, we spot many different features that make us, us. But there's one feature that's deeply important to who we are that can't be seen on the surface: the microbiome, the diverse and extraordinarily large community of microbes that call our innards home.
This spectacular hidden world is explored in a new exhibit, called "The Secret World Inside You," that opens today (Nov. 7) here at the American Museum of Natural History (AMNH).
Why is the microbiome such a significant part our make up? Consider the numbers: A census of all the trillions of cells inside our body shows that as few as one-tenth are human. The rest? Microbes. [Body Bugs: 5 Surprising Facts About Your Microbiome]
This doesn’t mean that human bodies are mostly made of microbes — human cells take up a lot more space. But even so, when combined, the microbial cells that coat our organs literally outweigh our brain.
In the new exhibit, visitors enter through a dark tunnel covered in glowing microbes. Inside, the exhibit’s walls are blanketed in a tissuelike pink mesh, making show-goers feel like they have been minituarized and ingested (akin to an episode of "The Magic School Bus").
One of the first electronic displays proclaims: "You’re not just an individual, you're an ecosystem." It's a recurring theme, and it's the heart of the show's message.
The centerpiece of the exhibition is a 14-foot-long (4.3 meters) interactive table. Projected onto it is a giant image of a human body that maps out where all our microbes live. The most bustling metropolis is, of course, the gut. People can touch the table to learn more about the lives of individual microbe species, including how they help us digest food, cause and fight infections and help regulate the immune system. The display also teaches the ecology of microbes. That is, how they work together to adapt, compete and collaborate.
Get the world’s most fascinating discoveries delivered straight to your inbox.

Seeing our microbes as part of a complex, diverse ecosystem is a new thing. Modern DNA sequencing technology has helped scientists survey our insides with unprecendented accuracy, revealing just how surprisingly vast the human microbiome is.
This kind of broader thinking is key to making the next medical breakthroughs, said Rob DeSalle, a geneticist and a co-curator at AMNH. "Medical researchers are going to have to become ecologists and think more and more about how these things are interacting," DeSalle told Live Science. [5 Ways Gut Bacteria Affect Your Health]
The role microbes play in human health is reinforced in the exhibit's other activities. A video game asks participants to choose between different foods to shoot into their stomachs as they watch how their choices change their microbiomes for better or worse. A card game called "Gutsy" challenges players to diversify their microbiome and fight off pathogens by drawing cards labeled "kiss," "antibiotic" and even "fecal transplant."
The show emphasizes how learning about the science of the microbiome can empower people. "It’s a medical breakthrough that we can go home and act upon," museum co-curator and microbiologist Susan Perkins told reporters in a media briefing on Wednesday (Nov. 4). "Understanding how the food we eat and the drugs we take changes our microbiome, gives us the power to do something that affects our own health."
But where there is a connection with health, there's also a lot of hype. It's important to note that the field of microbiomics is burgeoning, and there is still much to learn, scientists have said.
In designing the new exhibit, the show's curators took care to address this by expressing a balanced tone throughout. So, for instance, a display about probiotics points out that most supplements are limited because they don't contain bacteria that evolved to live inside the human body. And when the link between antibiotics and obesity rates is presented, the differences between correlation and causation are noted.
For a museum that is known for its displays and research on creatures like whales, dinosaurs, birds and mice, "The Secret World Inside You" offers a laser-focused glimpse of the inner workings of humans. There’s at least two good reasons why, according to museum officials. "In a museum we want to understand the full diversity of things," DeSalle said, "and our microbes have it over all of those organisms with respect to diversity."
"The show does have a human focus," Perkins added. "That’s because the museum is re-emerging as a leader in human health."
Tucked away in a corner of the exhibition is a tube of soil, stuffed with microbes from the world outside. Just like the unified microbiome initiative announcement last week, which calls for all microbe researchers from different fields to collaborate, the display draws attention to the growing connections between ecological and medical research. And from there, it becomes clear why the American Museum of Natural History is putting on a show that’s essentially about public health: The more we learn about what lives within us, the more we understand how the natural world affects our own wellbeing.
Follow Live Science @livescience, Facebook & Google+. Original article on Live Science.

 Live Science Plus
Live Science Plus